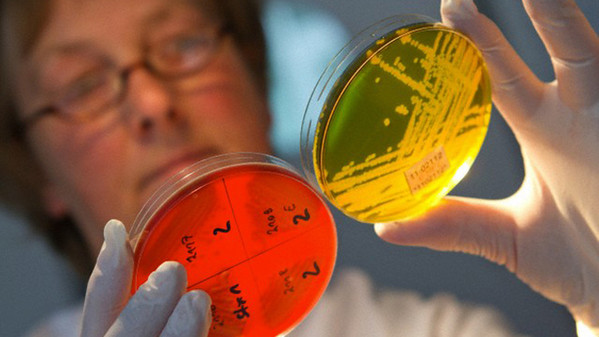

Il cibo può contaminarsi con batteri e virus in qualsiasi momento delle varie fasi della sua produzione, lavorazione, distribuzione o cattura. Ne evince un rischio di intossicazione alimentare, una condizione comune e piuttosto lieve che però per alcune persone può essere pericolosa o comunque provocare un serio malessere. Ma quali sono gli agenti infettivi contaminanti? E come agire con la prevenzione?